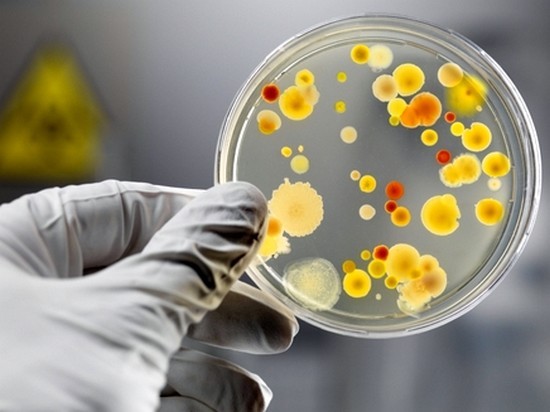

В западной Украине распространяется вирус «Коксаки» | |
![]() Иллюстрация Вирус Коксаки относится к группе вирусов, которые вызывают серьезное инфекционное заболевание
Вирус Коксаки поражает в основном детей до семи лет, он опасен своими осложнениями. В Тернополе и Львове зафиксировали сложные случаи массового поражения детей вирусом Коксаки. Об этом написал житель Тернополя Святослав Журовский, передаетОбозреватель. "В Тернополе сейчас эпидемия вируса Коксаки. Не лечится, надо переболеть. Ошибочно могут ставить диагноз "стоматит" и его лечить. Очень заразно. Лишний раз не посещайте людных мест и обязательно часто мойте руки, особенно это касается детей", - отметил Журовский. Эту информацию подтвердила и главный эпидемиолог Львовской области Наталия Тимко. Вирус Коксаки вызывает тяжелое инфекционное заболевание, но оно не настолько опасно, чтобы впадать в панику. Сегодня не существует противовирусных средств, которые могут помочь в его лечении, но ребенок выздоравливает самостоятельно спустя 3-4 дня после заражения. "Вирус Коксаки относится к группе вирусов, которые вызывают достаточно серьезное инфекционное заболевание. Оно сопровождается высокой температурой и сыпью. Температура может быть очень высокой. Плюс имеются признаки интоксикации – головная боль, плохой аппетит, вялость", - рассказывает семейный врач, педиатр Алексей Максименко. По его словам, за свою практику ни разу не сталкивался со случаями осложнений, "хотя в литературе описано, что, к сожалению, осложнения могут иметь место, в частности, такие тяжелые как энцефалит". Врач заверил: заболевание проходит "само по себе". "Так называемый инкубационный период, то есть время, прошедшее с момента попадания вируса в организм до развития клинических симптомов, составляет от нескольких часов до нескольких суток. Как правило, около суток. Обычно заболевание длится 3-4 дня, не больше недели. Потом температура падает", - рассказал он. | |
|
12.10.2016 в 13:09 1617 Здоровье | |
Сегодня читают
| Комментариев: 0 | |
Войдите, чтобы оставить комментарий.